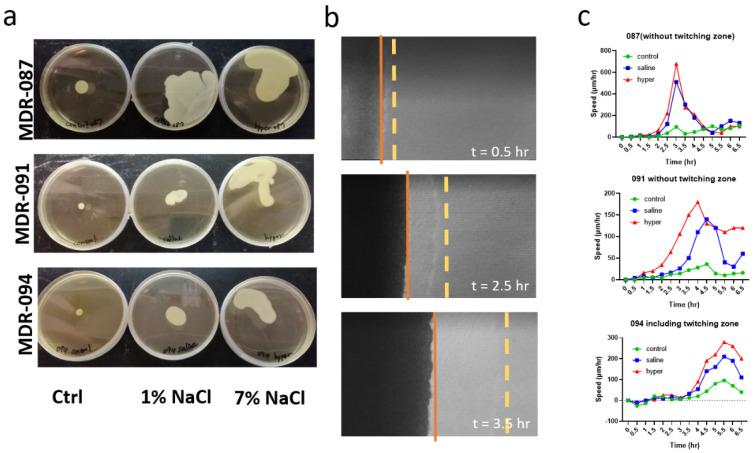

雾化高渗盐水可抑制生物膜形成,增强多重耐药菌的抗生素敏感性。
Aerosolized Hypertonic Saline Hinders Biofilm Formation to Enhance Antibiotic Susceptibility of Multidrug-Resistant .
作者信息
Lin Hui-Ling, Chiang Chen-En, Lin Mei-Chun, Kau Mei-Lan, Lin Yun-Tzu, Chen Chi-Shuo
机构信息
Department of Biomedical Engineering and Environmental Sciences, National Tsing Hua University, Hsinchu 300044, Taiwan.
Department of Respiratory Therapy, Chang Gung University, Taoyuan 33323, Taiwan.
出版信息
Antibiotics (Basel). 2021 Sep 15;10(9):1115. doi: 10.3390/antibiotics10091115.
Limited therapeutic options are available for multidrug-resistant (MDR-AB), and the development of effective treatments is urgently needed. The efficacy of four aerosolized antibiotics (gentamicin, amikacin, imipenem, and meropenem) on three different MDR-AB strains was evaluated using hypertonic saline (HS, 7 g/100 mL) as the aerosol carrier. HS aerosol effectively hindered biofilm formation by specific MDR-AB strains. It could also interrupt the swarming dynamics of MDR-AB and the production of extracellular polymeric substances, which are essential for biofilm progression. Biofilms protect the microorganisms from antibiotics. The use of HS aerosol as a carrier resulted in a decreased tolerance to gentamicin and amikacin in the biofilm-rich MDR-AB. Moreover, we tested the aerosol characteristics of antibiotics mixed with HS and saline, and results showed that HS enhanced the inhaled delivery dose with a smaller particle size distribution of the four antibiotics. Our findings demonstrate the potential of using "old" antibiotics with our "new" aerosol carrier, and potentiate an alternative therapeutic strategy to eliminate MDR-AB infections from a biofilm-disruption perspective.
对于多重耐药鲍曼不动杆菌(MDR-AB),可用的治疗选择有限,因此迫切需要开发有效的治疗方法。使用高渗盐水(HS,7 g/100 mL)作为气溶胶载体,评估了四种雾化抗生素(庆大霉素、阿米卡星、亚胺培南和美罗培南)对三种不同MDR-AB菌株的疗效。HS气溶胶有效地阻碍了特定MDR-AB菌株的生物膜形成。它还可以中断MDR-AB的群体运动动态以及细胞外聚合物的产生,而细胞外聚合物对于生物膜的进展至关重要。生物膜可保护微生物免受抗生素的影响。使用HS气溶胶作为载体可降低富含生物膜的MDR-AB对庆大霉素和阿米卡星的耐受性。此外,我们测试了与HS和盐水混合的抗生素的气溶胶特性,结果表明HS提高了四种抗生素的吸入给药剂量,且粒径分布更小。我们的研究结果证明了将“旧”抗生素与我们的“新型”气溶胶载体结合使用的潜力,并从生物膜破坏的角度提出了一种消除MDR-AB感染的替代治疗策略。